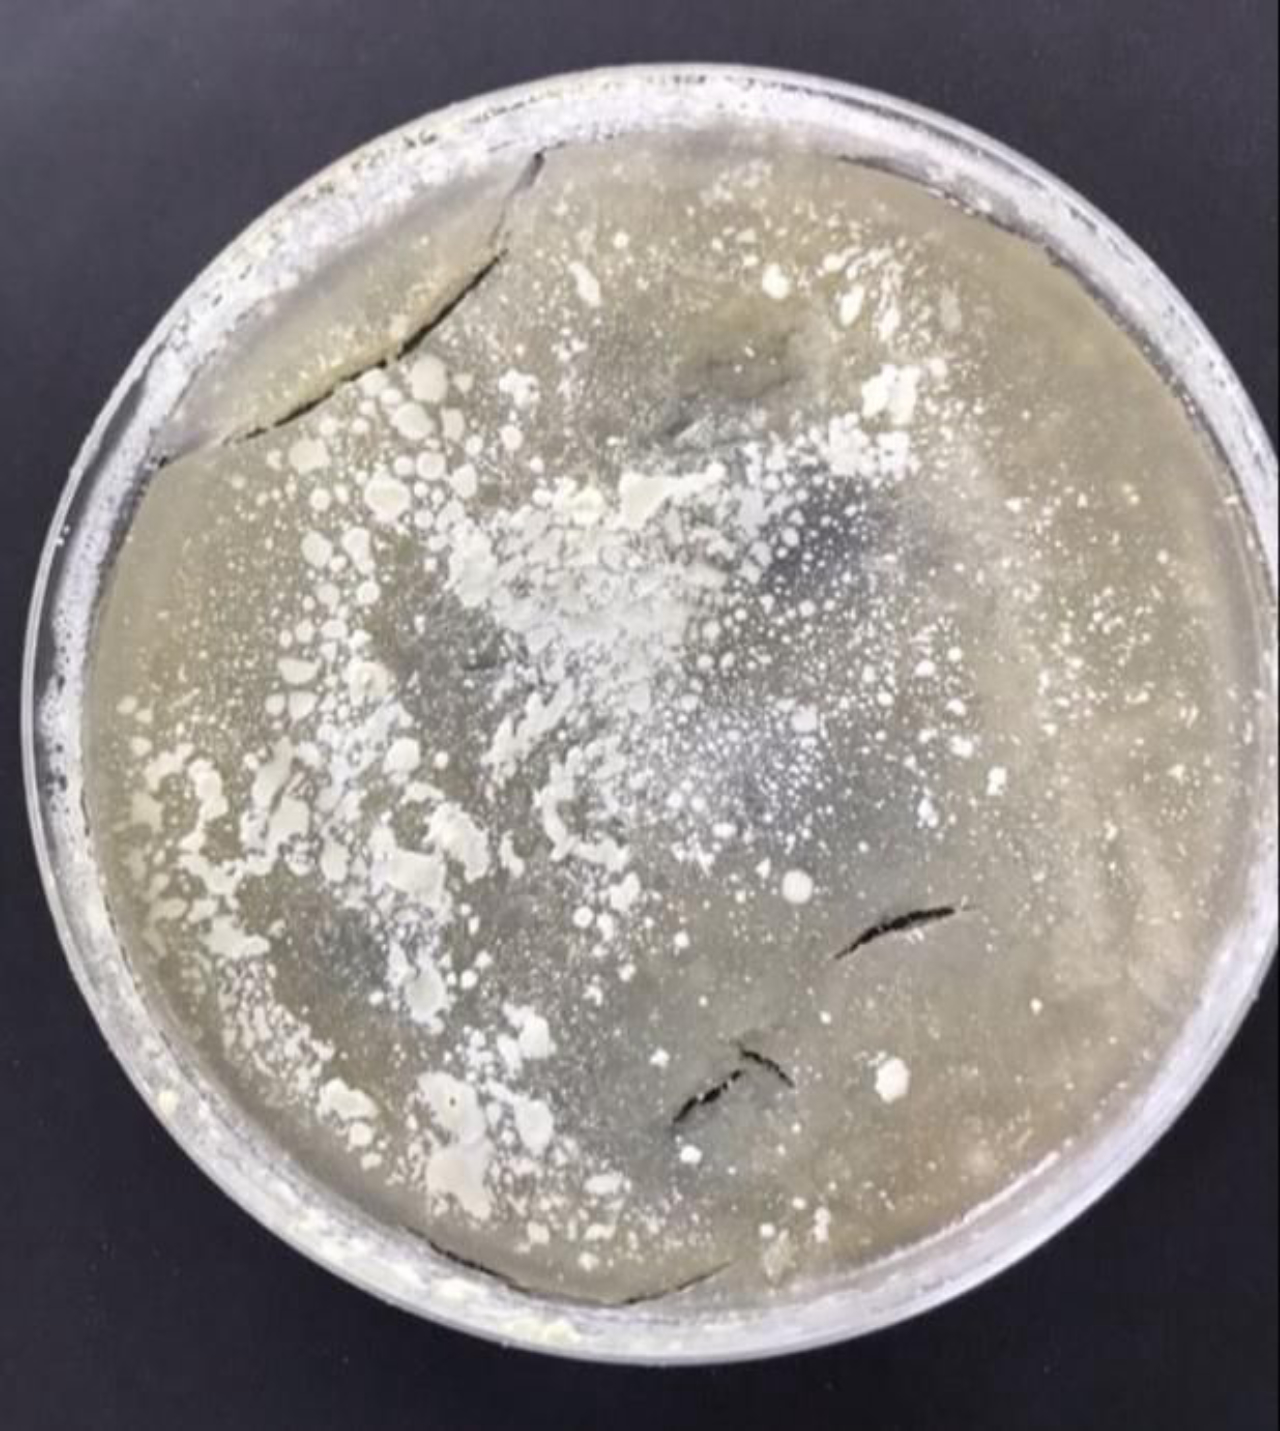
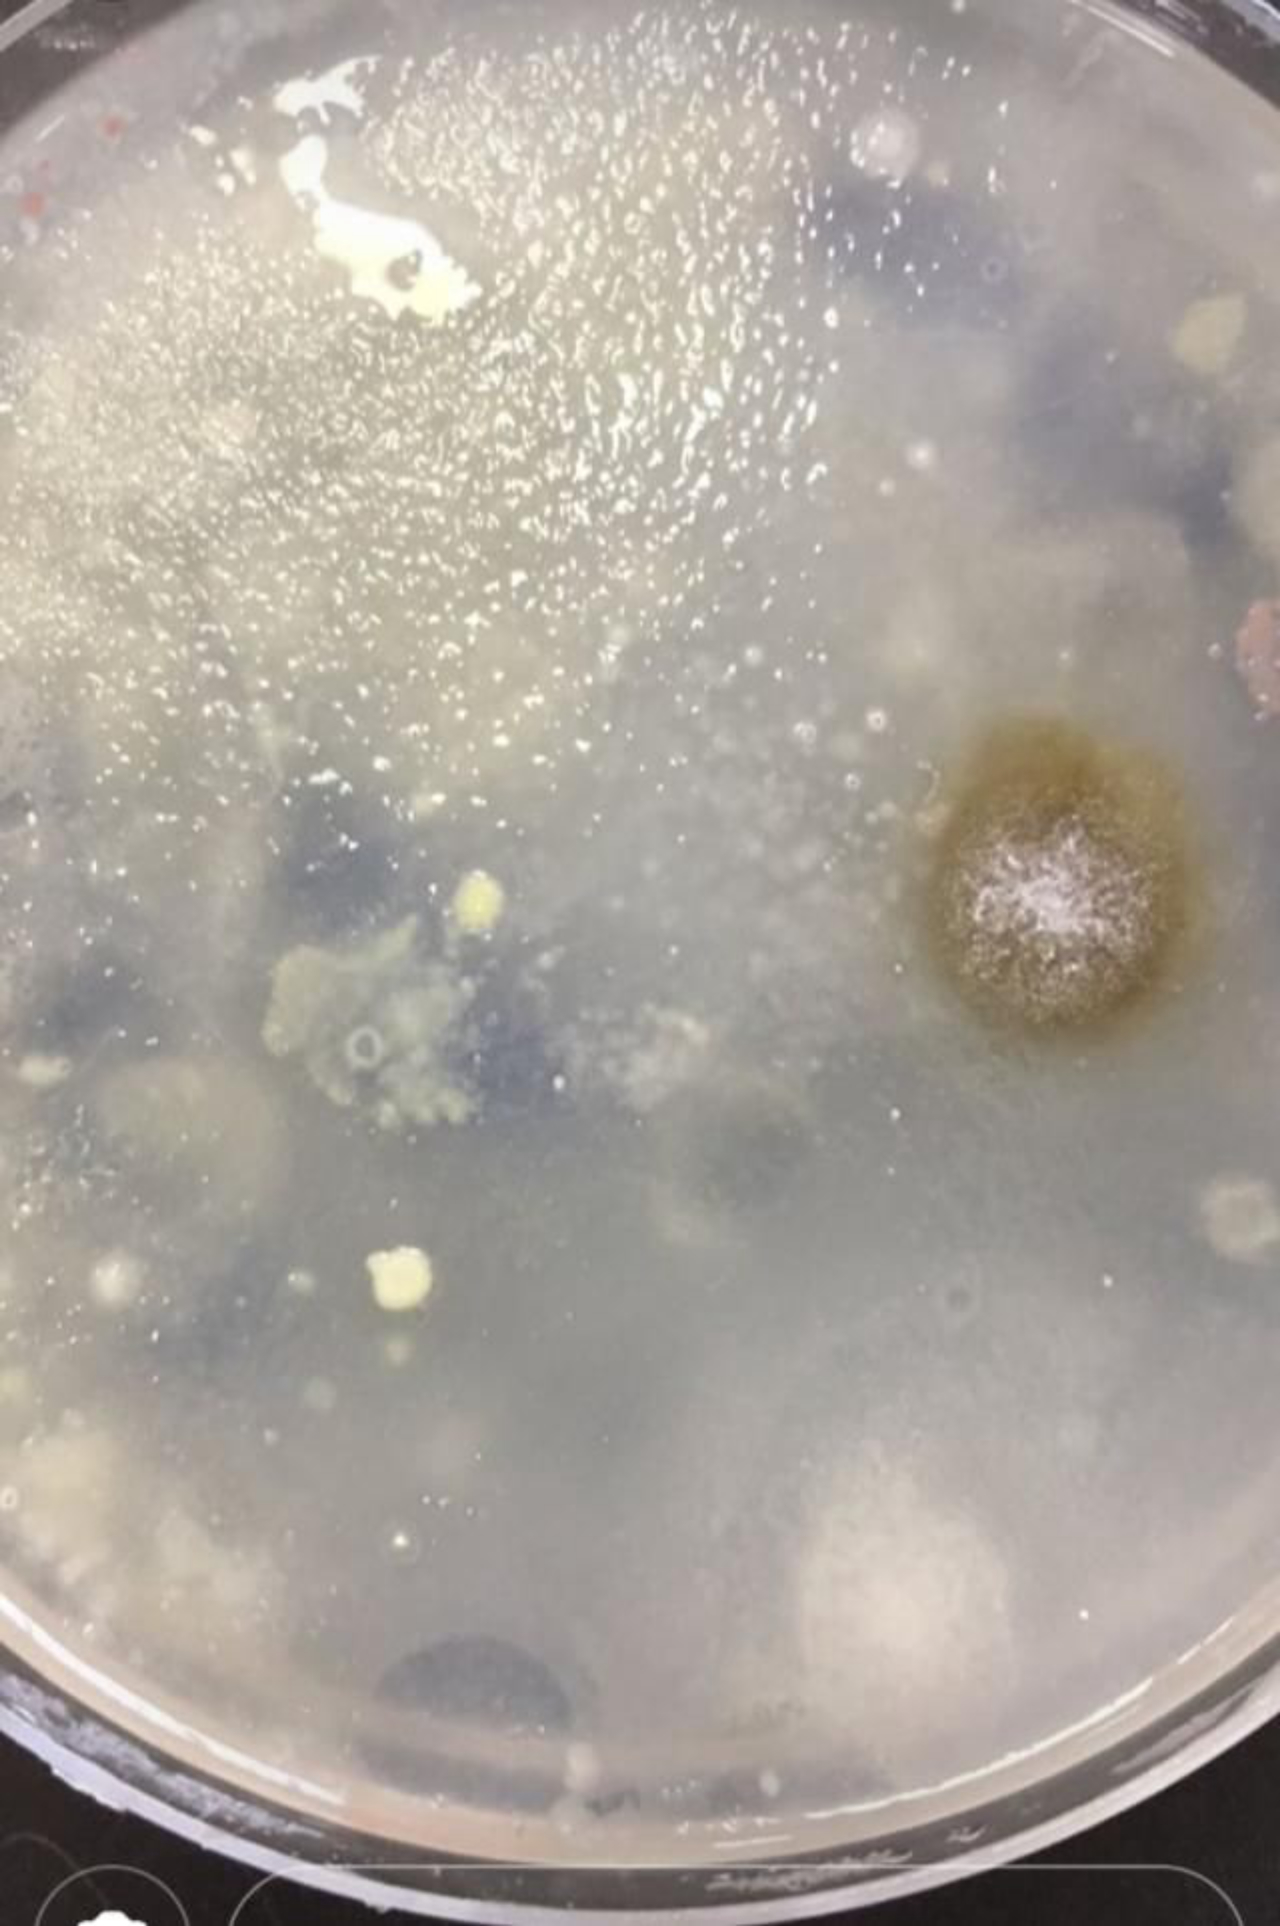

Saúde e Bem-Estar
Amanda Milléo
Quantas bactérias tem o slime? Professora faz experiência em sala de aula e conclusão assusta

Slimes podem conter tantas bactérias quanto objetos altamente manuseados, como celulares e controles remotos (Foto: Bigstock)
Febre entre as crianças, o slime (também conhecida como geleca) é facilmente encontrado. Não há quem não resista ao brinquedo gosmento, colorido e maleável, mas nem todos se lembram dos riscos à saúde que o brinquedo pode trazer. Bárbara Gionco Cano, professora de Ciências do colégio Marista, de Londrina (PR), também não tinha percebido tais perigos até que um colega professor a indagou: “quantas bactérias tem nesse slime?“.
A professora não sabia responder, mas na hora veio à mente as crianças mexendo no brinquedo enquanto comiam seus lanches, na hora do recreio da escola, bem como enchendo o slime com bolas de ar, tal qual um chiclete. Impecavelmente limpo, com certeza, o brinquedo não seria e Bárbara achou um jeito de incluir as crianças, os principais afetados, na busca pela resposta.

“Como estávamos estudando essa matéria com os alunos, e temos uma disciplina de Laboratório, levei os alunos para verificamos a quantidade de bactérias que tinha no slime. Dividimos em duas amostras: os slimes que foram limpos com álcool 70 e os slimes que não foram limpos, para vermos a diferença na proliferação de bactérias”, relata Bárbara.
Para a surpresa da professora, não houve diferença nenhuma. “O material não consegue ser limpo. Não significa que ele cause uma doença, mas é um reservatório de bactérias”, alerta.
A reação das crianças foi de bastante nojo, segundo Bárbara, mas se a esperança era de que eles parariam de mexer com o brinquedo durante as aulas, a constatação não afetou a rotina em nada. “Eles ficaram bem enojados, não acreditaram na hora ao ver a quantidade de bactérias, mas não pararam. A ideia, então, foi orientá-los a sempre que mexerem com o slime, lavar a mão depois e não colocar o brinquedo na boca”, diz Bárbara.
Slime tem tantas bactérias quanto celulares e controles remotos
A quantidade exata de bactérias não foi calculada, mas Bárbara estima que haviam bactérias na casa dos trilhões — tanto quanto há nos controles remotos e nos celulares.
“Não quantificamos, porque era uma quantia incontável. Também não trabalhamos com a amostra no sentido de descobrir as espécies de bactérias, mas olhando as colônias que se formaram, tem muitas bactérias da microbiota da mão. Isso não significa que não tenham bactérias de origem fecal. Dependendo da higiene da mão da criança, pode ter sim”, explica a professora, que também é doutora em Microbiologia.
O levantamento foi realizado em outubro de 2018 e os achados foram colocados em cartazes e expostos para todas as turmas do colégio.
LEIA TAMBÉM


